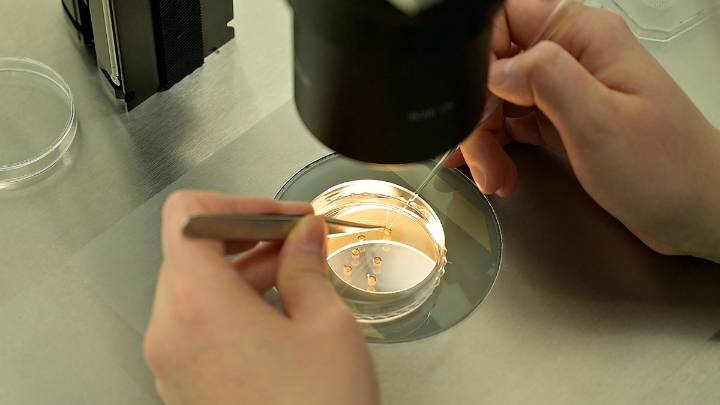
What's the best age for a woman to freeze her eggs? Doctors weigh in

Aging really messes with your head. One minute, you’re spiraling about the years flying by; the next, you’re hyping yourself up with affirmations like, “You’re only as old as you feel!” Personally, I feel 25 even though my feet are firmly planted in 30-something territory. Unfortunately, biology doesn’t care about my feelings, and lately, I’ve been wondering if my fertility agrees.
During a recent trip to my gynecologist, I admitted I was (quite) single and not currently interested in kids, but had been thinking about egg freezing in case I want them in the future. Unfortunately, cost — it can be up to $20,000 a cycle without insurance — is a major issue for me.
Stream Los Angeles News for free, 24/7, wherever you are. WATCH HERE
I expected my doctor to aggressively push me t

 NBC Southern California
NBC Southern California
Local News in Iowa
Local News in Iowa Raw Story
Raw Story Cover Media
Cover Media TODAY Health
TODAY Health AlterNet
AlterNet Reuters US Domestic
Reuters US Domestic NPR
NPR CNN Politics
CNN Politics